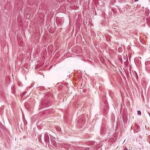

Junctional spitz nevus = وحمة سبيتز الوصلية
|
SPITZ NEVUS
Epidemiology
An annual incidence rate of 1.4 cases of Spitz nevus per 100,000 individuals has been estimated in Australia, compared with 25.4 per 100,000 individuals for cutaneous melanoma during the same time interval. Among melanocytic nevi excised in children, 1 percent to 8 percent of cases are interpreted as Spitz nevus. In a case series of 308 patients with Spitz nevi reported by Allen, 15 percent of lesions occurred in adolescents and adults, the oldest patient being 56 years of age. There appears to be no gender predilection for Spitz nevus. Published cases have been described primarily in whites. Etiology and Pathogenesis It may be presumed that Spitz nevi are derived from the same progenitor cells that give rise to epidermal melanocytes and nevomelanocytes. Unlike common
HISTORY The rate of growth, period of stabilization, and rate of regression of Spitz nevi are not known. The duration of solitary Spitz nevus before presentation is usually less than 9 months. Lesions usually show an increase in radial size over time, some gradual and others rapid. Based on patients with eruptive Spitz nevi, regression has been reported to occur and may even occur in some lesions while new lesions are appearing. CUTANEOUS LESIONS The most common variety of Spitz nevus is solitary, asymptomatic, pink or red, hairless, firm, and dome-shaped . Some Spitz nevi may resemble a keloid. The surface is commonly smooth, and the borders may fade into surrounding skin. Verrucous, scaly, stippled, crusted, or (rarely) eroded lesions have been noted. Spitz nevi are usually asymptomatic, but pruritus, tenderness, and/or bleeding may occur.82 A halo of depigmentation has been associated with several cases of Spitz nevus.33,88 Spitz nevi are part of a spectrum in which some also include PSCN and deep penetrating nevi. Spitz nevi can also present as widespread eruptive lesions or in a grouped manner as multiple agminated lesions consisting of red, red-brown, brown, or dark-brown papules or nodules, with a fine stippled surface . Agminated Spitz nevi often occur in the early years of life within a background of congenital (sometimes acquired) macular pigmentation (nevus spilus) or occasionally within a hypopigmented plaque. Spitz nevi may also develop as single or multiple lesions in a large CNN. The diameter of Spitz nevi ranges from several millimeters to several centimeters, the average being 8 mm in one series.82 In 73 percent of patients in one series,81 the tumor diameter was 6 mm or less, and in 94 percent of patients, the tumor diameter was less than 10 mm. Most cases are described as superficial papules or nodules, although subcutaneous involvement may occur.87 In one series of 43 patients,82 the anatomic location included the head or neck in 18, upper extremities in 9, torso in 9, and lower extremities in 7. Spitz nevi tend to spare palms, soles, and mucous membranes. RELATED PHYSICAL FINDINGS There is no known association with other somatic abnormalities. Laboratory Tests
HISTOPATHOLOGY Unlike ordinary nevi and melanomas, melanocytic cells in Spitz nevi are large—often twice the size of epidermal basal keratinocytes, with prominent mononuclear or multinucleated giant cells in the epidermis and/or dermis . Mitoses, usually few in number, are detected in one-half the cases, whereas atypical mitoses are uncommon in Spitz nevi. In contrast to melanoma, the melanocytic cells in Spitz nevi show progressive maturation with increasing depth, becoming smaller and more similar to ordinary nevomelanocytes, with the overall distribution of cells in the dermis being wedge-shaped, with narrowing of the wedge toward the subcutaneous fat. Coalescent eosinophilic globules (Kamino bodies), periodic acid-Schiff-positive and diastase-resistant (resembling colloid bodies), have been reported in 60 percent of Spitz nevi. Similar globules may be detected in 2 percent of melanomas and 0.9 percent of typical acquired nevi, but the globules are smaller in size, more difficult to find, single rather than coalescent, and commonly periodic acid-Schiff-negative. Melanocytic elements are usually arranged in well-circumscribed nests, although there may be permeation of the epidermis by single cells or small groups of cells. In those cases with epidermal nests, artifactual clefts are usually seen above the nests in half the cases, a finding rarely observed in melanoma. The epidermis is usually hyperplastic, with elongated and bulbous pegs and knobs extending into the dermis, although thinning and even ulceration may occur rarely. The dermal inflammatory cell infiltrate may be slight or marked, band-like, and mainly at the base or patchy around blood vessels and/or intermixing with tumor cells. Although melanin was observed in all 13 patients originally described by Spitz, more recent studies have determined that melanin was moderate in 10 percent of cases and heavy in 5 percent.88 Although the bizarre histopathologic features and frequent occurrence of dermal inflammation may cause diagnostic confusion, Spitz nevus usually can be differentiated from melanoma. The histologic features of Spitz nevus in children and adults are similar. SPECIAL TESTS A subgroup of Spitz nevi have a gain of chromosome 11p and amplification or activation of H-RAS. These markers are not routinely used in the clinical setting but may be helpful in the future for discriminating these nevi from other melanocytic neoplasias.
Complications Misinterpretation of benign or malignant behavior of the lesion could result in unnecessary or insufficient treatment, respectively. Prognosis and Clinical Course The natural history of the Spitz nevus is largely unknown. Based on patients with eruptive Spitz nevi, it is clear that spontaneous regression can occur. A concern is that some lesions diagnosed as Spitz nevi may progress to melanoma or represent melanoma at the outset. Differential Diagnosis of Spitz Nevi
Treatment Complete excision with a clear margin of normal skin is generally sufficient treatment for Spitz nevi. Given the difficulty of confidently excluding the possibility of melanoma in certain cases, a wider margin of normal skin may be prudent for histopathologically worrisome lesions.90 Incompletely excised lesions may recur in as many as 7 percent to 16 percent of patients.82,91-93 Although some authors have advocated sentinel node biopsies in these lesions, this may only add to the confusion because Spitz nevus cells may be present in the regional lymph nodes but not necessarily indicate malignancy.94 Management of patients who have numerous Spitz nevi requires individual judgment and periodic examination for new or unstable lesions. Prevention The role of UVR exposure in the development or progression of Spitz nevi is unknown. |